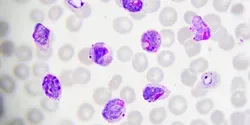
malaria parasites

human health


A newly developed spectroscopy method is helping to clarify the poorly understood molecular process by which an anti-HIV drug induces lethal mutations in the virus’ genetic material. The findings from the University of Chicago and the Massachusetts Institute of Technology could bolster efforts to develop the next generation of anti-viral treatments.

Research from the University of Manchester using cutting edge computer analysis reveals that despite mutating, Ebola hasn’t evolved to become deadlier since the first outbreak 40 years ago.

Consumers are one step closer to benefiting from packaging that could give simple text warnings when food is contaminated with deadly pathogens like E. coli and Salmonella, and patients could soon receive real-time diagnoses of infections such as C. difficile right in their doctors’ offices, saving critical time and trips to the lab.